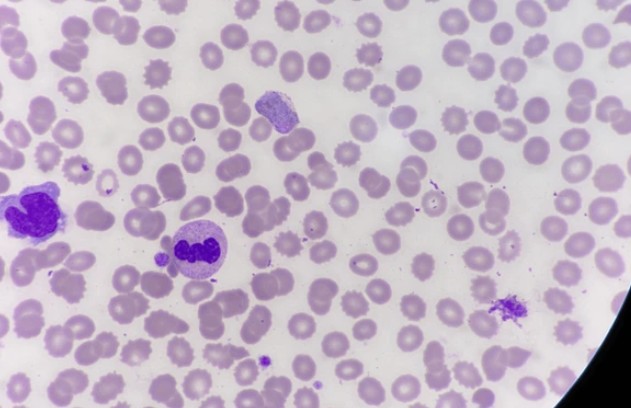

말라리아 증상|경보|예방법|예방접종 가격|약|전염|모기|치료법

말라리아는 인류 역사상 가장 오래되고 치명적인 전염병 중 하나로, 주로 열대와 아열대 지역에서 발생합니다. 말라리아 원인은 ‘플라스모디움(Plasmodium)’이라는 기생충이며, 이는 ‘암컷 얼룩날개모기(Anopheles)’를 통해 사람에게 전파됩니다. 감염되면 발열, 오한, 빈혈, 황달 등의 증상이 나타나며 치료하지 않으면 사망에 이를 수 있습니다. 매년 전 세계 수억 명이 감염되고 수십만 명이 목숨을 잃는 심각한 질병이므로, 여행자와 현지 거주자 모두 철저한 예방이 필요합니다. 최근 말라리아 백신이 개발되었지만 아직 완벽한 방어 수단은 아니므로, 모기 차단과 예방약 복용이 병행되어야 합니다. 오늘 이 시간에는 말라리아 초기증상 / 말라리아 증상 / 말라리아 경보 / 예방방법 / 말라리아 예방접종 / 예방약 / 말라리아 예방접종 비용 / 전염 여부 / 말라리아 모기 / 말라리아 치료방법에 대해서 이야기 나누어 보겠습니다.
말라리아 초기 증상
① 감기와 비슷
초기에는 미열, 두통, 피로감 등 감기와 유사한 증상이 나타나 혼동하기 쉽습니다.
② 가벼운 증상
처음에는 증상이 약하게 느껴져 간과하기 쉽고, 이 때문에 조기 진단을 놓치기 쉽습니다.
③ 잠복기
일반적으로 모기에 물린 뒤 7~14일 후 증상이 발현되며, 일부 경우에는 수주에서 수개월까지 잠복하기도 합니다.
④ 여행자 주의
말라리아 지역을 방문하고 귀국 후 이런 증상이 나타난다면 반드시 의료진에게 알리는 것이 중요합니다.




말라리아 증상
① 주기적 발열
고열과 오한, 발한이 일정한 주기로 반복되는 것이 말라리아의 대표적 특징입니다.
② 소화기 증상
구토, 설사, 메스꺼움 등 위장관 증상이 동반되며 전신 쇠약감을 심화시킵니다.
③ 혈액 관련 증상
기생충이 적혈구를 파괴하면서 빈혈과 황달이 발생하고 심하면 장기 손상으로 이어집니다.
④ 신경계 증상
중증 말라리아에서는 혼수, 발작, 정신 혼란 등 뇌 말라리아 증상이 나타나며 치명적일 수 있습니다.




말라리아 경보
① 계절적 경보
우기철처럼 모기 번식이 활발한 시기에는 말라리아 감염 위험이 크게 증가합니다.
② 지역별 경보
아프리카 사하라 이남, 동남아시아, 남미 등은 고위험 지역으로 지정되어 주기적으로 경보가 발령됩니다.
③ 여행자 정보
외교부와 질병관리청에서 제공하는 여행경보를 확인해야 하며, 특히 장기 체류자는 더욱 철저히 대비해야 합니다.
④ 현지 주민 주의
정부의 방역 활동에 협조하고, 모기장과 살충제를 적극적으로 사용해야 안전합니다.




말라리아 예방 방법
① 모기장 사용
살충제가 처리된 모기장을 사용하면 야간 모기 흡혈을 효과적으로 차단할 수 있습니다.
② 생활습관 관리
긴 옷을 착용하고 노출 부위에는 모기 기피제를 발라야 하며, 특히 밤 시간대에 주의가 필요합니다.
③ 환경 관리
고인 물, 웅덩이, 논 주변 등 모기 번식지를 제거해 모기 개체 수를 줄여야 합니다.
④ 예방약 복용
말라리아 발생 국가를 방문하는 경우 출발 전부터 예방약을 복용하는 것이 필수적입니다.

말라리아 예방접종 • 예방약 • 접종 비용
① 백신 종류
현재 WHO가 승인한 말라리아 백신은 ‘RTS,S(모스키릭스)’와 ‘R21/Matrix-M’ 두 가지입니다.
② 효과
백신은 일정 부분 방어 효과가 있으나 100% 예방은 불가능하므로 다른 방법과 병행해야 합니다.
③ 예방약 종류
클로로퀸, 아토바쿠온-프로구아닐, 독시사이클린, 메플로퀸 등이 있으며, 방문 지역에 따라 권장 약이 다릅니다.
④ 비용
백신 접종 비용은 국가마다 다르며 보통 수십 달러에서 100달러 이상 소요됩니다. 예방약 비용도 약 종류와 기간에 따라 수만 원에서 수십만 원까지 다양합니다.


말라리아 전염 여부
① 모기 매개
말라리아는 사람 간 직접 전염되지 않으며 반드시 모기 매개를 통해 감염됩니다.
② 수혈 감염
드물게 수혈이나 장기 이식, 오염된 주사기를 통해 감염될 수 있습니다.
③ 수직 감염
임산부에서 태아로 감염이 전파되는 경우도 보고되었습니다.
④ 전염 특징
결국 말라리아는 모기 방제를 통해서만 확실히 차단할 수 있는 질병입니다.


말라리아 모기
① 모기 종류
말라리아를 옮기는 모기는 ‘암컷 얼룩날개모기(Anopheles)’입니다.
② 활동 시간
이 모기는 주로 밤에 활동하며, 조용히 접근해 사람의 혈액을 흡입합니다.
③ 서식지
늪, 논, 웅덩이 등 고인 물에서 번식하며 우기철에 개체 수가 급격히 증가합니다.
④ 특징
일반 모기와 달리 소리 없이 다가오기 때문에 물린 사실을 인지하지 못하는 경우가 많습니다.
말라리아는 여전히 매년 수억 명을 감염시키고 수십만 명을 사망에 이르게 하는 심각한 감염병입니다. 단순한 열병으로 생각해서는 안 되며, 예방과 조기 치료가 생명을 지키는 핵심 요소입니다. 여행자와 현지 거주자 모두 모기 차단, 예방약 복용, 백신 접종을 병행해야 안전합니다. 백신이 개발되면서 희망이 보이고 있지만 아직은 완전한 예방이 어려우므로 경각심을 가져야 합니다. 개인적인 노력뿐 아니라 국제적인 협력과 보건 인프라 강화가 필수적입니다. 결국 말라리아는 인류가 끝까지 극복해야 할 공동의 과제라 할 수 있습니다.
2025.05.19 - [증상과 예방] - 니파 바이러스 증상|초기 증상|박쥐|감염 경로|치료|예방|관련주
니파 바이러스 증상|초기 증상|박쥐|감염 경로|치료|예방|관련주
니파 바이러스 증상|초기 증상|박쥐|감염 경로|치료|예방|관련주니파 바이러스(Nipah virus)는 1998년 말레이시아에서 처음 보고된 인수공통 감염 바이러스로, 박쥐가 주요 자연숙주로 알려
homeostasises.com
2025.05.20 - [증상과 예방] - 대상포진 예방접종 가격|초기 증상|치료 방법|전염|예방|좋은 음식
대상포진 예방접종 가격|초기 증상|치료 방법|전염|예방|좋은 음식
대상포진 예방접종 가격|초기 증상|치료 방법|전염|예방|좋은 음식대상포진은 수두 바이러스인 수두-대상포진 바이러스(Varicella Zoster Virus)가 신경에 잠복해 있다가 면역력이 약해질 때
homeostasises.com
2025.07.04 - [증상과 예방] - 백일해 예방 접종|초기 증상|예방|시기|가격|치료|격리|격리기간
백일해 예방 접종|초기 증상|예방|시기|가격|치료|격리|격리기간
백일해 예방 접종|초기 증상|예방|시기|가격|치료|격리|격리기간백일해(百日咳, Pertussis)는 보르데텔라 백일해균(Bordetella pertussis)*에 의해 발생하는 급성 호흡기 감염병으로, 특히 영유
homeostasises.com
'증상과 예방' 카테고리의 다른 글
| 인후염 증상|원인|치료법|예방|빨리 낫는법|좋은 음식|좋은 습관 (0) | 2025.09.25 |
|---|---|
| 구순염 증상|원인|치료법|연고|빨리 낫는법|좋은 음식|예방 습관 (0) | 2025.09.25 |
| 해파리 쏘였을때 증상|해파리 종류|응급 처치|치료|바르는 약|예방 (5) | 2025.08.17 |
| 더위 먹었을때 증상|치료법|더위 예방법|빨리 낫는법|회복 좋은 음식 (3) | 2025.07.28 |
| 열사병 증상|응급 처치|열사병 일사병 차이|치료|예방법|좋은 음식 (0) | 2025.07.24 |